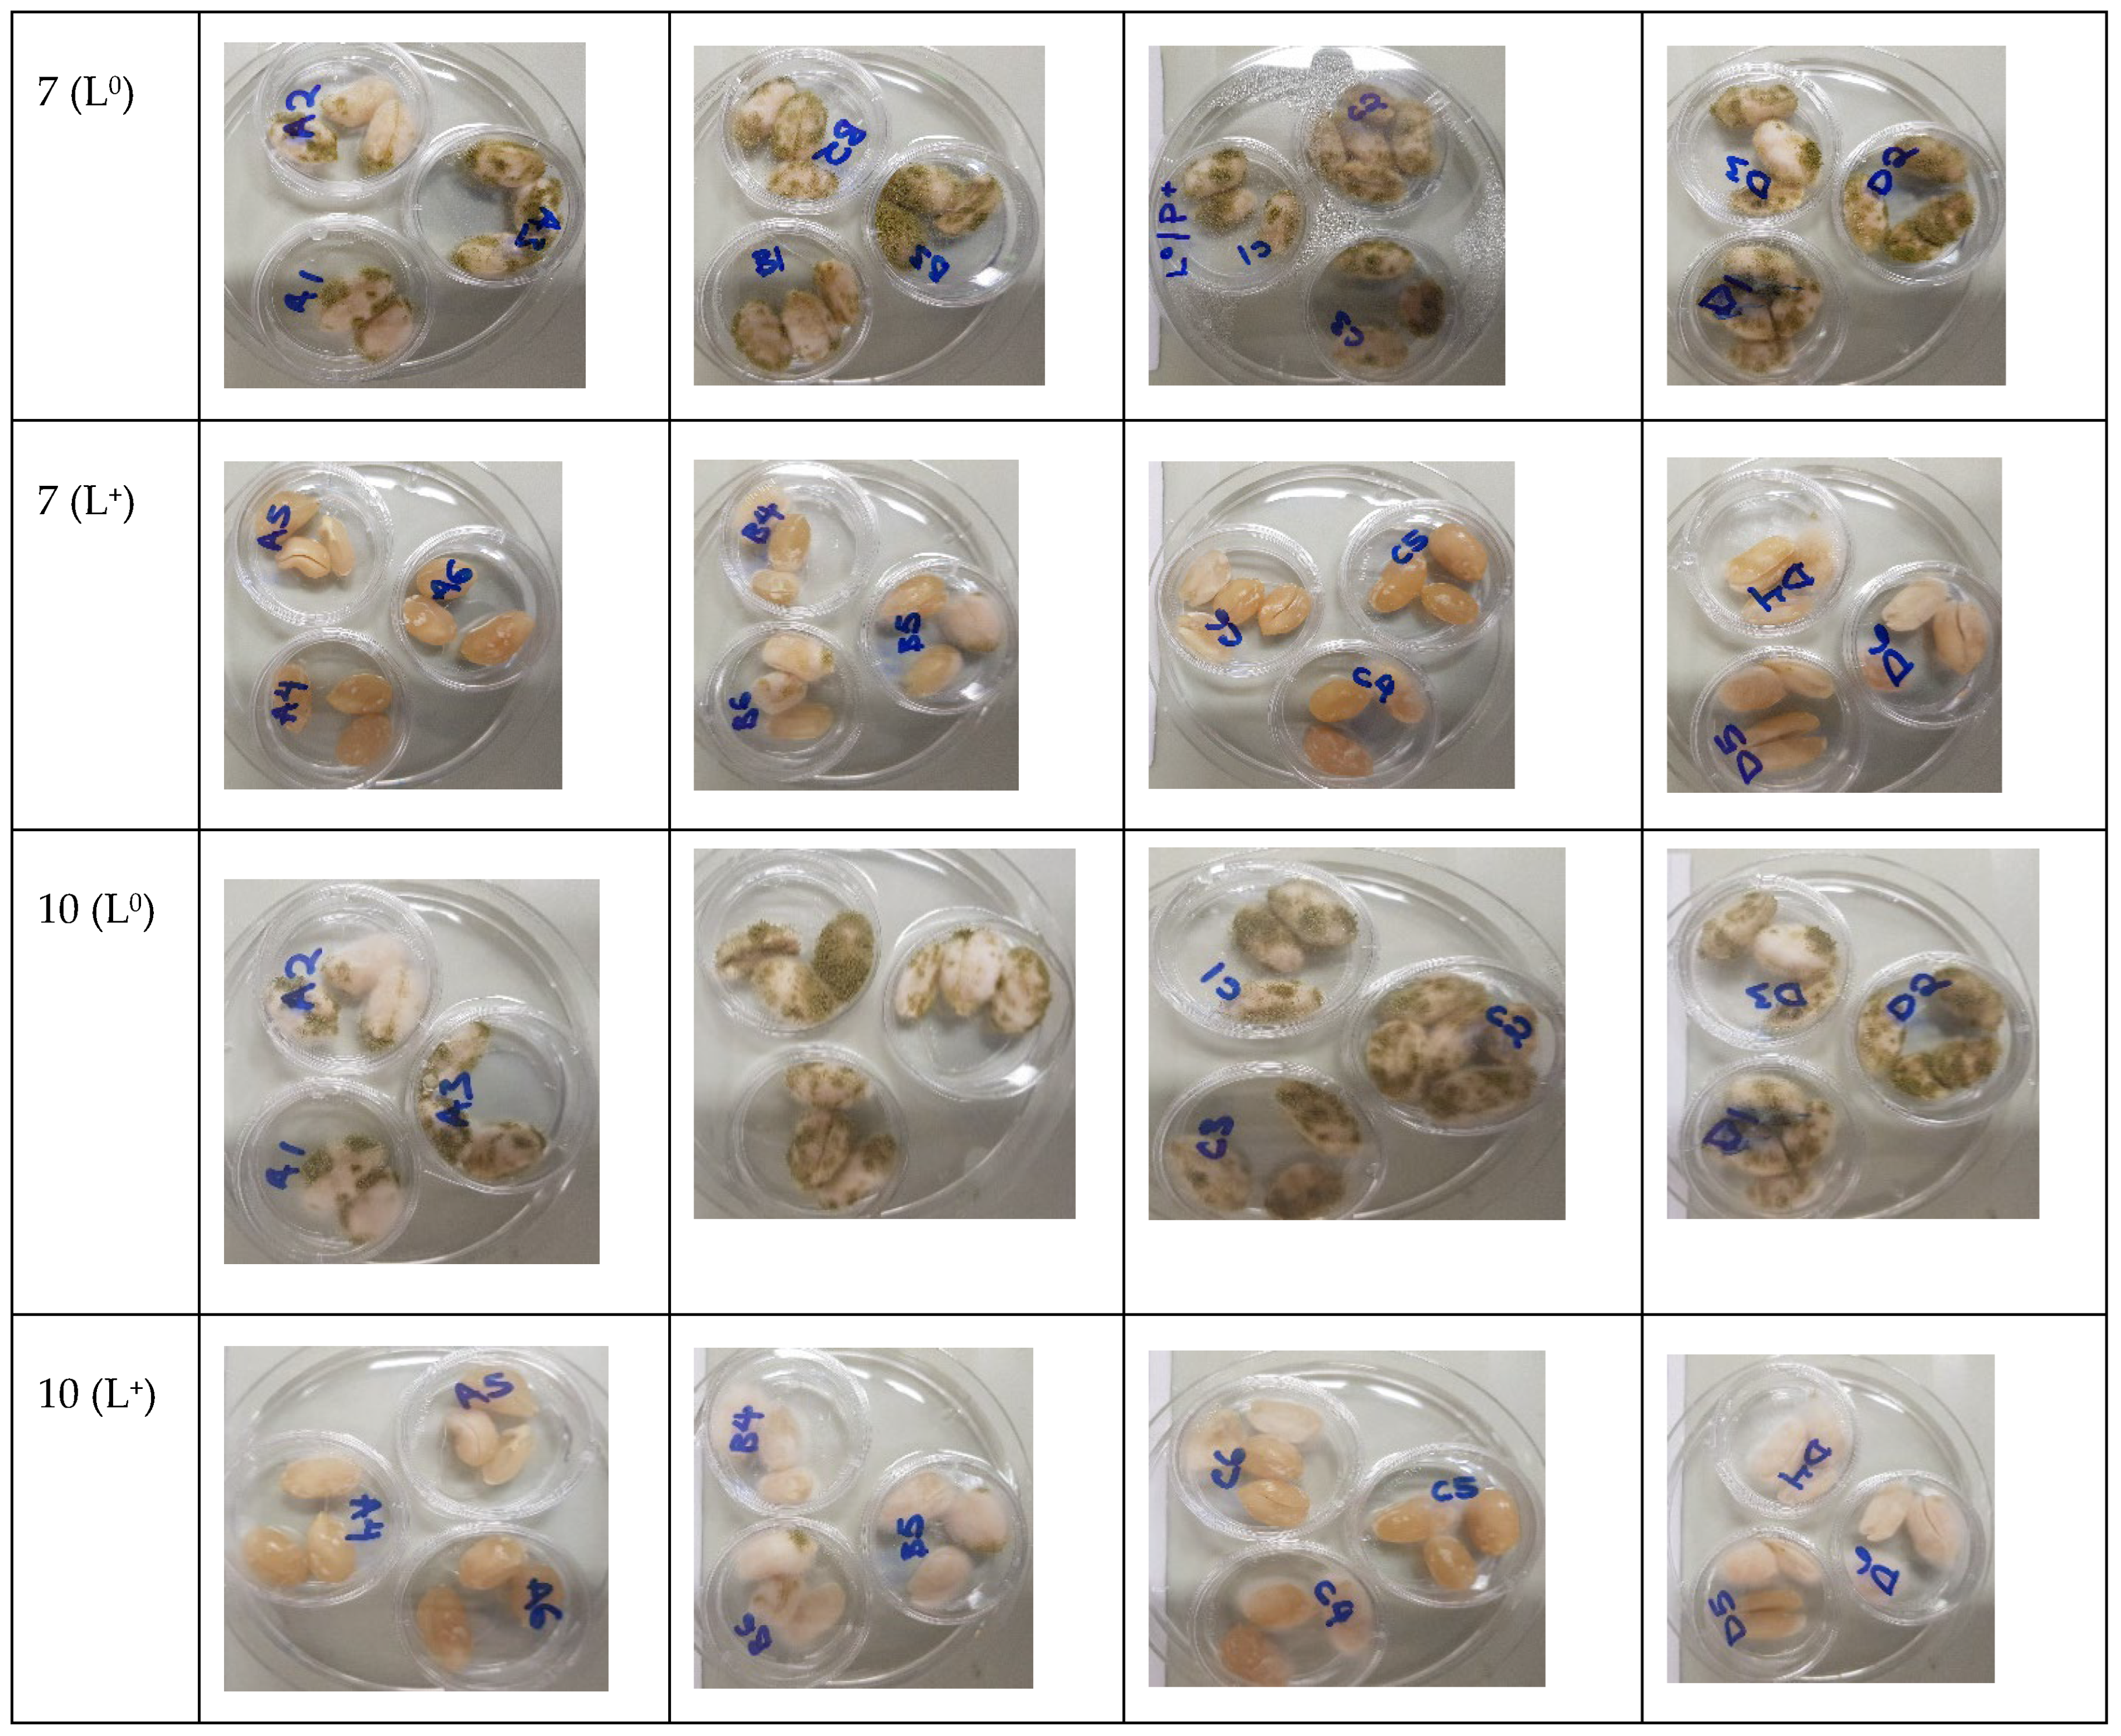
Foods 11 00354 g003b

Curcumin-Based Photosensitization, a Green Treatment in Inactivating Aspergillus flavus Spores in Peanuts
Abstract
:1. Introduction
2. Materials and Methods
2.1. Culture Preparation
2.2. Photosensitizer and Light Source
2.3. Photoinactivation of Fungal Spores in Suspension
2.4. Photodecontamination of Inoculated Peanuts
2.4.1. Sample Preparation
2.4.2. Photosensitization Treatment
2.4.3. Aflatoxin Analysis in Peanuts
2.5. Statistical Analysis
3. Results and Discussion
3.1. Photoinactivation of Fungal Spores in Suspension
3.2. Photodecontamination of Inoculated Peanuts
3.3. Effect of Curcumin-Based Photosensitization on Aflatoxin B1 Generation
4. Conclusions
Author Contributions
Funding
Institutional Review Board Statement
Informed Consent Statement
Data Availability Statement
Acknowledgments
Conflicts of Interest
Appendix A. Supplementary Data

References
- Shibli, S.; Siddique, F.; Raza, S.; Ahsan, Z.; Raza, I. Chemical composition and sensory analysis of peanut butter from indigenous peanut cultivars of Pakistan. Pak. J. Agric. Res. 2019, 32, 159–169. [Google Scholar] [CrossRef]
- Bonku, R.; Yu, J. Health aspects of peanuts as an outcome of its chemical composition. Food Sci. Hum. Wellness 2020, 9, 21–30. [Google Scholar] [CrossRef]
- Mupunga, I.; Mngqawa, P.; Katerere, D.R. Peanuts, aflatoxins and undernutrition in children in Sub-Saharan Africa. Nutrients 2017, 9, 1287. [Google Scholar] [CrossRef] [PubMed] [Green Version]
- Sun, D.; Mao, J.; Wang, Z.; Li, H.; Zhang, L.; Zhang, W.; Zhang, Q.; Li, P. Inhibition of Aspergillus flavus growth and aflatoxins production on peanuts over α-Fe2O3 nanorods under sunlight irradiation. Int. J. Food Microbiol. 2021, 353, 109296. [Google Scholar] [CrossRef]
- Diener, U.L.; Cole, R.J.; Sanders, T.H.; Payne, G.A.; Lee, L.S.; Klich, M.A. Epidemiology of aflatoxin formation by Aspergillus flavus. Annu. Rev. Phytopathol. 1987, 25, 249–270. [Google Scholar] [CrossRef]
- Nayak, S.N.; Agarwal, G.; Pandey, M.K.; Sudini, H.K.; Jayale, A.S.; Purohit, S.; Desai, A.; Wan, L.; Guo, B.; Liao, B. Aspergillus flavus infection triggered immune responses and host-pathogen cross-talks in groundnut during in-vitro seed colonization. Sci. Rep. 2017, 7. [Google Scholar] [CrossRef] [Green Version]
- Squire, R.A. Ranking animal carcinogens: A proposed regulatory approach. Science 1981, 214, 877–880. [Google Scholar] [CrossRef]
- Manhando, E.; Zhou, Y.; Wang, F. Early Detection of Mold-Contaminated Peanuts Using Machine Learning and Deep Features Based on Optical Coherence Tomography. AgriEngineering 2021, 3, 703–715. [Google Scholar] [CrossRef]
- Bennett, J.W.; Klich, M. Mycotoxins. Clin. Microbiol. Rev. 2003, 16, 497–516. [Google Scholar] [CrossRef] [Green Version]
- Norlia, M.; Nor-Khaizura, M.; Selamat, J.; Abu Bakar, F.; Radu, S.; Chin, C.K. Evaluation of aflatoxin and Aspergillus sp. contamination in raw peanuts and peanut-based products along this supply chain in Malaysia. Food Addit. Contam. Part A 2018, 35, 1787–1802. [Google Scholar] [CrossRef]
- Hoeltz, M.; Einloft, T.C.; Oldoni, V.P.; Dottori, H.A.; Noll, I.B. The occurrence of aflatoxin B1 contamination in peanuts and peanut products marketed in southern Brazil. Braz. Arch. Biol. Technol. 2012, 55, 313–317. [Google Scholar] [CrossRef] [Green Version]
- Commission, E. Commission Regulation (EC) No 165/2010 of 26 February 2010 amending Regulation (EC) No 1881/2006 setting maximum levels for certain contaminants in foodstuffs as regards aflatoxins. Off. J. Eur. Union 2010, 50, 8–12. [Google Scholar]
- Boni, S.; Beed, F.; Kimanya, M.; Koyano, E.; Mponda, O.; Mamiro, D.; Kaoneka, B.; Bandyopadhyay, R.; Korie, S.; Mahuku, G. Aflatoxin contamination in Tanzania: Quantifying the problem in maize and groundnuts from rural households. World Mycotoxin J. 2021, 14, 553–564. [Google Scholar] [CrossRef]
- Food Standards Australia New Zealand(FSANZ). Australia New Zealand Food Standards Code—Schedule 19—Maximum Levels of Contaminants and Natural Toxicants; Federal Register of Legislation: Kingston, ACT, Australia, 2017.
- Luksiene, Z.; Brovko, L. Antibacterial photosensitization-based treatment for food safety. Food Eng. Rev. 2013, 5, 185–199. [Google Scholar] [CrossRef]
- Hadi, J.; Wu, S.; Brightwell, G. Antimicrobial Blue Light versus Pathogenic Bacteria: Mechanism, Application in the Food Industry, Hurdle Technologies and Potential Resistance. Foods 2020, 9, 1895. [Google Scholar] [CrossRef]
- Huang, L.; Yong, K.W.; Fernando, W.C.; Carpinelli de Jesus, M.; De Voss, J.J.; Sultanbawa, Y.; Fletcher, M.T. The Inactivation by Curcumin-Mediated Photosensitization of Botrytis cinerea Spores Isolated from Strawberry Fruits. Toxins 2021, 13, 196. [Google Scholar] [CrossRef] [PubMed]
- Song, L.; Zhang, F.; Yu, J.; Wei, C.; Han, Q.; Meng, X. Antifungal effect and possible mechanism of curcumin mediated photodynamic technology against Penicillium expansum. Postharvest Biol. Technol. 2020, 167, 111234. [Google Scholar] [CrossRef]
- Al-Asmari, F.; Mereddy, R.; Sultanbawa, Y. The effect of photosensitization mediated by curcumin on storage life of fresh date (Phoenix dactylifera L.) fruit. Food Control 2018, 93, 305–309. [Google Scholar] [CrossRef] [Green Version]
- Temba, B.A.; Fletcher, M.T.; Fox, G.P.; Harvey, J.J.; Sultanbawa, Y. Inactivation of Aspergillus flavus spores by curcumin-mediated photosensitization. Food Control 2016, 59, 708–713. [Google Scholar] [CrossRef]
- Nguenha, R.; Damyeh, M.S.; Phan, A.D.; Hong, H.T.; Chaliha, M.; O’Hare, T.J.; Netzel, M.E.; Sultanbawa, Y. Effect of Photosensitization Mediated by Curcumin on Carotenoid and Aflatoxin Content in Different Maize Varieties. Appl. Sci. 2021, 11, 5902. [Google Scholar] [CrossRef]
- Nguenha, R.J.; Damyeh, M.S.; Hong, H.T.; Chaliha, M.; Sultanbawa, Y. Effect of solvents on curcumin as a photosensitizer and its ability to inactivate Aspergillus flavus and reduce aflatoxin B1 in maize kernels and flour. J. Food Process. Preserv. 2021, 46, e16169. [Google Scholar] [CrossRef]
- Temba, B.A.; Fletcher, M.T.; Fox, G.P.; Harvey, J.; Okoth, S.A.; Sultanbawa, Y. Curcumin-based photosensitization inactivates Aspergillus flavus and reduces aflatoxin B1 in maize kernels. Food Microbiol. 2019, 82, 82–88. [Google Scholar] [CrossRef]
- Glueck, M.; Schamberger, B.; Eckl, P.; Plaetzer, K. New horizons in microbiological food safety: Photodynamic Decontamination based on a curcumin derivative. Photochem. Photobiol. Sci. 2017, 16, 1784–1791. [Google Scholar] [CrossRef] [PubMed] [Green Version]
- Filbert, M.E.; Brown, D.L. Aflatoxin contamination in Haitian and Kenyan peanut butter and two solutions for reducing such contamination. J. Hunger Environ. Nutr. 2012, 7, 321–332. [Google Scholar] [CrossRef]
- Lukšiene, Ž.; Pečiulyte, D.; Jurkoniene, S.; Puras, R. Inactivation of possible fungal food contaminants by photosensitization. Food Technol. Biotechnol. 2005, 43, 335–341. [Google Scholar]
- Bhavya, M.; Hebbar, H. Efficacy of blue LED in microbial inactivation: Effect of photosensitization and process parameters. Int. J. Food Microbiol. 2019, 290, 296–304. [Google Scholar] [CrossRef] [PubMed]
- Tortik, N.; Spaeth, A.; Plaetzer, K. Photodynamic decontamination of foodstuff from Staphylococcus aureus based on novel formulations of curcumin. Photochem. Photobiol. Sci. 2014, 13, 1402–1409. [Google Scholar] [CrossRef]
- Maclean, M.; MacGregor, S.J.; Anderson, J.G.; Woolsey, G. Inactivation of bacterial pathogens following exposure to light from a 405-nanometer light-emitting diode array. Appl. Environ. Microbiol. 2009, 75, 1932–1937. [Google Scholar] [CrossRef] [Green Version]
- Sulyok, M.; Berthiller, F.; Krska, R.; Schuhmacher, R. Development and validation of a liquid chromatography/tandem mass spectrometric method for the determination of 39 mycotoxins in wheat and maize. Rapid Commun. Mass Spectrom. 2006, 20, 2649–2659. [Google Scholar] [CrossRef]
- Wainwright, M.; Byrne, M.N.; Gattrell, M.A. Phenothiazinium-based photobactericidal materials. J. Photochem. Photobiol. B Biol. 2006, 84, 227–230. [Google Scholar] [CrossRef]
- Barr, H.; MacRobert, A.; Tralau, C.; Boulos, P.; Bown, S. The significance of the nature of the photosensitizer for photodynamic therapy: Quantitative and biological studies in the colon. Br. J. Cancer 1990, 62, 730–735. [Google Scholar] [CrossRef] [PubMed] [Green Version]
- Wainwright, M. Photodynamic antimicrobial chemotherapy (PACT). J. Antimicrob. Chemother. 1998, 42, 13–28. [Google Scholar] [CrossRef] [PubMed]
- Yi, B.; Ka, H.J.; Kim, M.-J.; Lee, J. Effects of curcumin on the oxidative stability of oils depending on type of matrix, photosensitizers, and temperature. J. Am. Oil Chem. Soc. 2015, 92, 685–691. [Google Scholar] [CrossRef]
- Luksiene, Z.; Buchovec, I.; Paskeviciute, E. Inactivation of food pathogen Bacillus cereus by photosensitization in vitro and on the surface of packaging material. J. Appl. Microbiol. 2009, 107, 2037–2046. [Google Scholar] [CrossRef] [PubMed]
- Francisco, M.L.D.; Resurreccion, A. Functional components in peanuts. Crit. Rev. Food Sci. Nutr. 2008, 48, 715–746. [Google Scholar] [CrossRef]
- Jahanshiri, Z.; Shams-Ghahfarokhi, M.; Allameh, A.; Razzaghi-Abyaneh, M. Effect of curcumin on Aspergillus parasiticus growth and expression of major genes involved in the early and late stages of aflatoxin biosynthesis. Iran. J. Public Health 2012, 41, 72. [Google Scholar]
- Sharma, M.; Manoharlal, R.; Puri, N.; Prasad, R. Antifungal curcumin induces reactive oxygen species and triggers an early apoptosis but prevents hyphae development by targeting the global repressor TUP1 in Candida albicans. Biosci. Rep. 2010, 30, 391–404. [Google Scholar] [CrossRef]
- Elmnasser, N.; Guillou, S.; Leroi, F.; Orange, N.; Bakhrouf, A.; Federighi, M. Pulsed-light system as a novel food decontamination technology: A review. Can. J. Microbiol. 2007, 53, 813–821. [Google Scholar] [CrossRef] [Green Version]
- Ghate, V.; Ng, K.; Zhou, W.; Yang, H.; Khoo, G.; Yoon, W.-B.; Yuk, H.-G. Antibacterial effect of light emitting diodes of visible wavelengths on selected foodborne pathogens at different illumination temperatures. Int. J. Food Microbiol. 2013, 166, 399–406. [Google Scholar] [CrossRef] [PubMed]
- Darko, C.; Mallikarjunan, P.K.; Kaya-Celiker, H.; Frimpong, E.A.; Dizisi, K. Effects of packaging and pre-storage treatments on aflatoxin production in peanut storage under controlled conditions. J. Food Sci. Technol. 2018, 55, 1366–1375. [Google Scholar] [CrossRef]

Publisher’s Note: MDPI stays neutral with regard to jurisdictional claims in published maps and institutional affiliations. |
© 2022 by the authors. Licensee MDPI, Basel, Switzerland. This article is an open access article distributed under the terms and conditions of the Creative Commons Attribution (CC BY) license (https://creativecommons.org/licenses/by/4.0/).
Share and Cite
Mukubesa, N.; Nguenha, R.; Hong, H.T.; Seididamyeh, M.; Netzel, M.E.; Sultanbawa, Y. Curcumin-Based Photosensitization, a Green Treatment in Inactivating Aspergillus flavus Spores in Peanuts. Foods 2022, 11, 354. https://doi.org/10.3390/foods11030354
Mukubesa N, Nguenha R, Hong HT, Seididamyeh M, Netzel ME, Sultanbawa Y. Curcumin-Based Photosensitization, a Green Treatment in Inactivating Aspergillus flavus Spores in Peanuts. Foods. 2022; 11(3):354. https://doi.org/10.3390/foods11030354
Chicago/Turabian StyleMukubesa, Nalukui, Rafael Nguenha, Hung T. Hong, Maral Seididamyeh, Michael E. Netzel, and Yasmina Sultanbawa. 2022. "Curcumin-Based Photosensitization, a Green Treatment in Inactivating Aspergillus flavus Spores in Peanuts" Foods 11, no. 3: 354. https://doi.org/10.3390/foods11030354
APA StyleMukubesa, N., Nguenha, R., Hong, H. T., Seididamyeh, M., Netzel, M. E., & Sultanbawa, Y. (2022). Curcumin-Based Photosensitization, a Green Treatment in Inactivating Aspergillus flavus Spores in Peanuts. Foods, 11(3), 354. https://doi.org/10.3390/foods11030354

